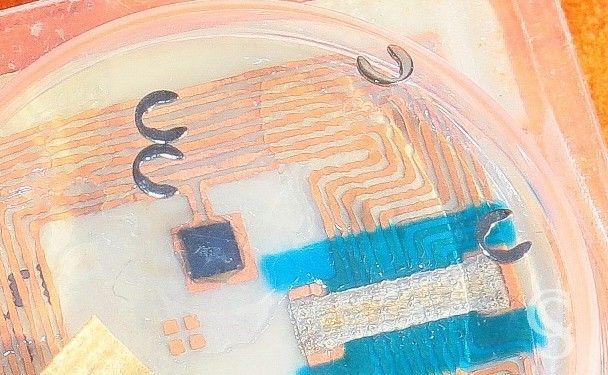

- On sale!
Rolex OEM Factory Watch spare for sale furniture part.5066-1 spring clip for cal.3035, 3000
Rolex Genuine Watch spare for sale furniture :
Rolex #part.5066-1 springs clip for cal.3035, 3000.
x 5 pieces in package.
#B5066-1-Y5
-
 Garanties sécurité (à modifier dans le module "Réassurance")
Garanties sécurité (à modifier dans le module "Réassurance")
-
 Politique de livraison (à modifier dans le module "Réassurance")
Politique de livraison (à modifier dans le module "Réassurance")
-
 Politique retours (à modifier dans le module "Réassurance")
Politique retours (à modifier dans le module "Réassurance")
Rolex Genuine & Rare Watch spare 5066-1 for sale furniture :
Rolex #part.5066-1
Lot of 5 x springs clip for Rolex automatic movements #.3035, 3000.
x 5 pieces in package ref B5066-1-Y5.
Perfect for to repair, service or restore.
GUARANTEED TO BE 1OO% ORIGINAL